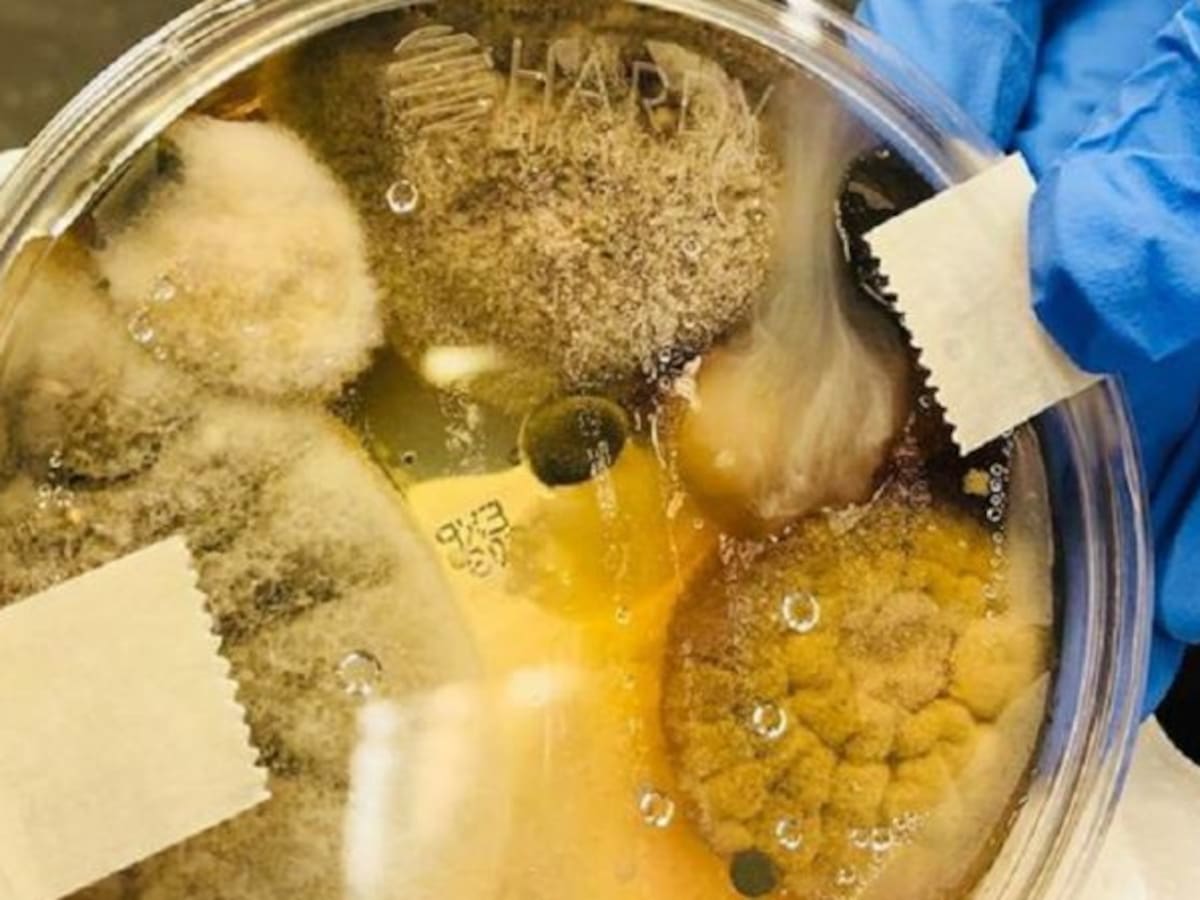

Detectan en la estación espacial china una bacteria nunca antes vista en la Tierra: se adapta a condiciones extremas
La Niallia tiangongensis fue encontrada en la cabina de control y sobrevive a la microgravedad, la radiación y la escasez de nutrientes
25/05/2025 - 01:08
Redacción